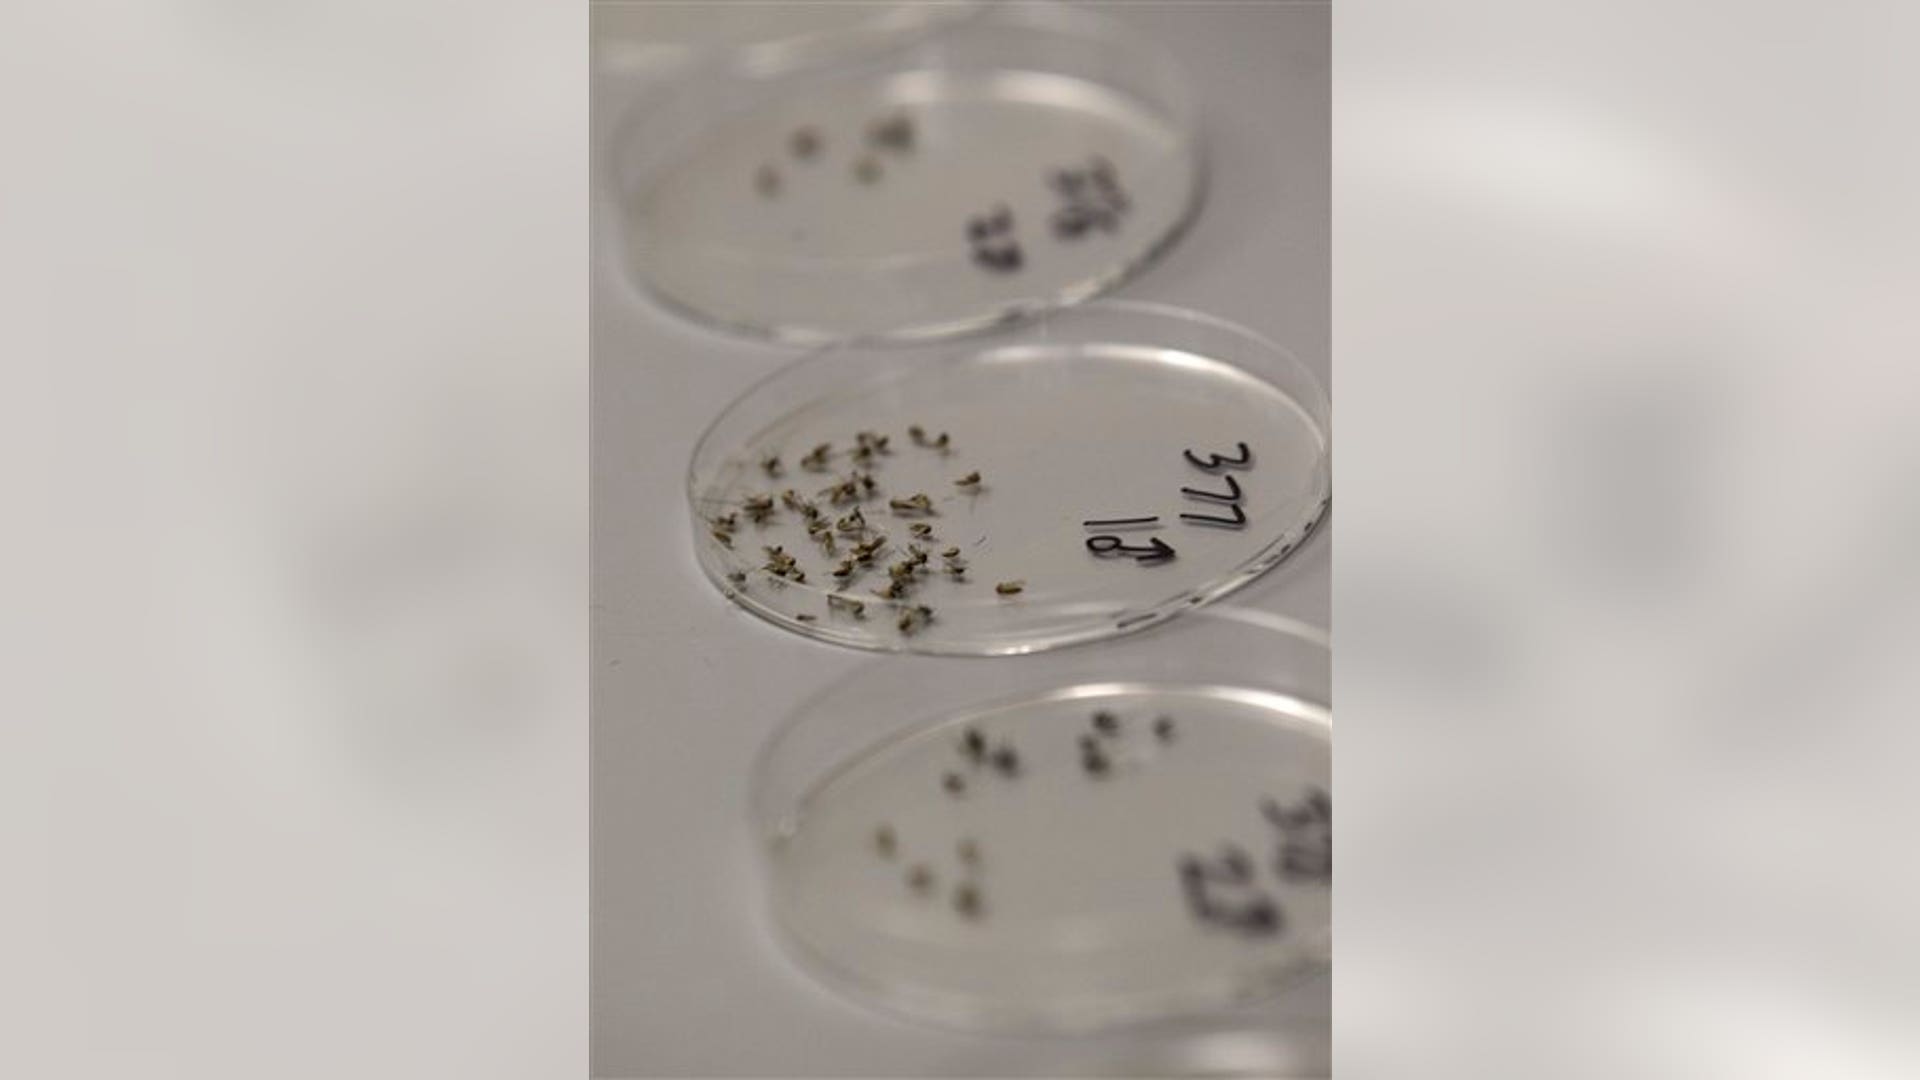
West_Nile_5

Move Back
ADVERTISEMENT
Skip- Published8 Images
West Nile: Mosquito War Begins
For the first time in more than 45 years, Dallas County has launched an aerial assault on the flying pests.
![West_Nile_4]()
![West_Nile_7]()
![West_Nile_6]()
![West_Nile_8]()
![West_Nile_2]()
![West_Nile_3]()
![West_Nile_1]()
![West_Nile_5]()
- Published8 Images
West Nile: Mosquito War Begins
For the first time in more than 45 years, Dallas County has launched an aerial assault on the flying pests.
Move Forward
- West Nile: Mosquito War Begins








Thumbnail View
Image 0 of 8